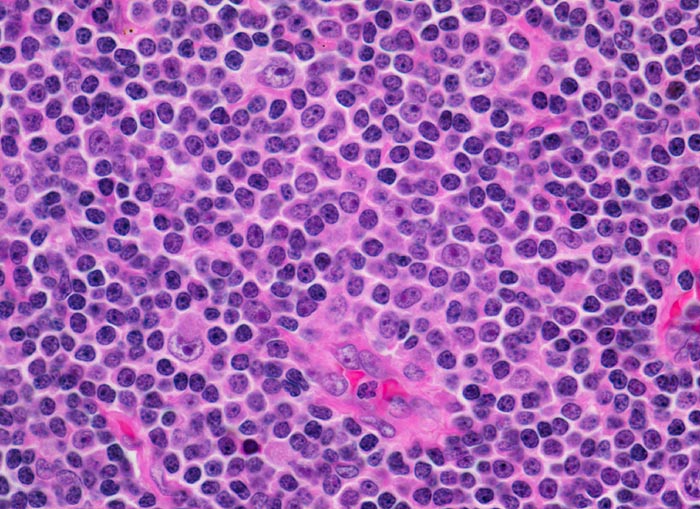

PathoPic – image database / PathoPic ID 3929 - chronische lymphozytische Leukämie vom B-Zell Typ
de
Diagnose
chronische lymphozytische Leukämie vom B-Zell Typ
Diagnose Gruppe
maligner Tumor
Topographie
Lymphknoten, inguinal
Topographie Gruppe
Lymphatische Gewebe, KM, Milz
Beschreibung
Ausschnitt aus einem Proliferationszentrum (Pseudofollikel) mit drei Zellpopulationen:
Kleine Lymphozyten mit wenig Zytoplasma und verklumptem dichtem Chromatin.
Etwas grössere Prolymphozyten mit feiner verteiltem Chromatin und kleinen Nukleolen.
Grosse Paraimmunoblasten mit runden bis ovalen Kernen, fein verteiltem Chromatin und einem zentralen Nukleolus.
Kleine Lymphozyten mit wenig Zytoplasma und verklumptem dichtem Chromatin.
Etwas grössere Prolymphozyten mit feiner verteiltem Chromatin und kleinen Nukleolen.
Grosse Paraimmunoblasten mit runden bis ovalen Kernen, fein verteiltem Chromatin und einem zentralen Nukleolus.
Klinik
Asymptomatische Patientin mit generalisierter Lymphknotenvergrösserung. Zufallsbefund.
Bilder Typ
Histologie
Vergrösserung
630
Alter
82
Geschlecht
unbekannt
Datum
Ersteintrag: 20.01.2002
Update: 04.02.2024